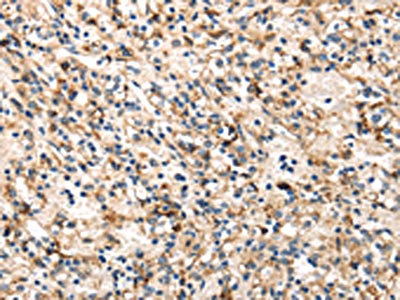

TRIB3 Antibody
-
中文名稱:TRIB3兔多克隆抗體
-
貨號:CSB-PA120599
-
規(guī)格:¥1100
-
圖片:
-
The image on the left is immunohistochemistry of paraffin-embedded Human liver cancer tissue using CSB-PA120599(TRIB3 Antibody) at dilution 1/30, on the right is treated with fusion protein. (Original magnification: ×200)
-
The image on the left is immunohistochemistry of paraffin-embedded Human prostate cancer tissue using CSB-PA120599(TRIB3 Antibody) at dilution 1/30, on the right is treated with fusion protein. (Original magnification: ×200)
-
-
其他:
產(chǎn)品詳情
-
Uniprot No.:
-
基因名:
-
別名:C20orf97 antibody; Neuronal cell death inducible putative kinase antibody; Neuronal cell death-inducible putative kinase antibody; NIPK antibody; p65 interacting inhibitor of NF-kappaB antibody; p65-interacting inhibitor of NF-kappa-B antibody; SINK antibody; SKIP 3 antibody; SKIP3 antibody; TRB 3 antibody; TRB-3 antibody; TRB3 antibody; TRIB 3 antibody; Trib3 antibody; TRIB3_HUMAN antibody; Tribbles homolog 3 antibody; Tribbles pseudokinase 3 antibody; Tribbles3 antibody
-
宿主:Rabbit
-
反應(yīng)種屬:Human
-
免疫原:Full length fusion protein
-
免疫原種屬:Homo sapiens (Human)
-
標(biāo)記方式:Non-conjugated
-
抗體亞型:IgG
-
純化方式:Antigen affinity purification
-
濃度:It differs from different batches. Please contact us to confirm it.
-
保存緩沖液:-20°C, pH7.4 PBS, 0.05% NaN3, 40% Glycerol
-
產(chǎn)品提供形式:Liquid
-
應(yīng)用范圍:ELISA,IHC
-
推薦稀釋比:
Application Recommended Dilution ELISA 1:2000-1:5000 IHC 1:25-1:100 -
Protocols:
-
儲存條件:Upon receipt, store at -20°C or -80°C. Avoid repeated freeze.
-
貨期:Basically, we can dispatch the products out in 1-3 working days after receiving your orders. Delivery time maybe differs from different purchasing way or location, please kindly consult your local distributors for specific delivery time.
-
用途:For Research Use Only. Not for use in diagnostic or therapeutic procedures.
相關(guān)產(chǎn)品
靶點(diǎn)詳情
-
功能:Inactive protein kinase which acts as a regulator of the integrated stress response (ISR), a process for adaptation to various stress. Inhibits the transcriptional activity of DDIT3/CHOP and is involved in DDIT3/CHOP-dependent cell death during ER stress. May play a role in programmed neuronal cell death but does not appear to affect non-neuronal cells. Acts as a negative feedback regulator of the ATF4-dependent transcription during the ISR: while TRIB3 expression is promoted by ATF4, TRIB3 protein interacts with ATF4 and inhibits ATF4 transcription activity. Disrupts insulin signaling by binding directly to Akt kinases and blocking their activation. May bind directly to and mask the 'Thr-308' phosphorylation site in AKT1. Interacts with the NF-kappa-B transactivator p65 RELA and inhibits its phosphorylation and thus its transcriptional activation activity. Interacts with MAPK kinases and regulates activation of MAP kinases. Can inhibit APOBEC3A editing of nuclear DNA.
-
基因功能參考文獻(xiàn):
- A link between TRIB3 and the stereotypical pattern of gray matter loss in Alzheimer's disease. PMID: 29511103
- the R141 site of TRIB3 dictates the strength of Akt binding but does not affect other Trbl-dependent developmental processes, suggesting a specificity that could serve as a drug target for metabolic diseases. PMID: 29025897
- TRB3 is overexpressed in lesions of patients with psoriasis. PMID: 28790132
- tribbles pseudokinase 3 (TRB3) and sestrin 2 may contribute to the development of obesity and its complications and can be considered interesting therapeutic target for the treatment of obesity PMID: 28639842
- TRIB3, a single-domain protein with impaired kinase catalytic activity, has been described to perform a complex of roles, many of which are likely to be cell type-specific. (Review) PMID: 28393700
- High TRB3 expression is associated with basal-like breast cancer. PMID: 27593927
- TRIB3 promotes acute promyelocytic leukemia progression through stabilization of the oncoprotein PML-RARalpha and inhibition of p53-mediated senescence. PMID: 28486108
- Downregulation of TRIB3 is associated with lung cancer. PMID: 28184934
- This study aims to investigate whether the Tribbles 3 Q84R polymorphism has profound effects on serum semaphorin 3E and what effect semaphorin 3E exerts on carotid atherosclerosis. PMID: 28249916
- overexpression of TRIB3 is associated with tumor angiogenesis and a poor prognosis in patients with gastric cancer (GC) . Our findings indicate that TRIB3 is a promising target for antiangiogenic therapy in GC. PMID: 27573078
- Our findings suggest that good glucose and blood pressure control exhibited greater benefits on vascular outcomes in patients with TRIB3 (rs2295490) G allele. PMID: 27793583
- In this exploratory analysis, IRS1, ENNP1 and TRIB3, known to be associated with type 2 diabetes and harboring genes playing a prominent role in mediating insulin signaling, may modulate a number of cardiometabolic phenotypes in patients of Italian ancestry with newly-diagnosed type 2 diabetes. PMID: 26868433
- TRIB3 acts as a crucial 'stress adjusting switch' that links homeostasis, metabolic disease and cancer; and is being actively investigated as a disease biomarker and therapeutic target PMID: 26855171
- TRB3 is upregulated in macrophages upon treatment with ox-LDL. TRB3 promotes lipid accumulation and suppresses cytokine expression, suggesting inflammation and foam cell formation can be reciprocally regulated. PMID: 26584255
- Studies suggest that pseudo-kinase family of tribbles (TRIB) proteins TRIB1, TRIB2 and TRIB3 play roles in pathogenesis of rheumatoid arthritis (RA) and osteoarthritis. PMID: 26517922
- Studies suggest that pseudo-kinase family of tribbles (TRIB) proteins TRIB1, TRIB2 and TRIB3 were involved in the pathogenesis of inflammation. PMID: 26517925
- Studies indicate that small molecules can reveal rate-limiting signalling outputs and functions of pseudo-kinase family of tribbles (TRIB) proteins TRIB1, TRIB2 and TRIB3 in cells and intact organisms, serving as guides for the development of new drugs. PMID: 26517930
- Studies suggest that the tribbles homolog 3 (Drosophila) protein (TRIB3) Q84R missense polymorphis contributes to atherosclerosis. PMID: 26517932
- Studies show a remarkable reduction in tribbles 2 protein (Trib2) expression during oocyte maturation whereas tribbles 1 protein (Trib1) and tribbles 3 protein (Trib3) expression was significantly increased during this process. PMID: 26517934
- Studies show that tribbles pseudokinase 3 (TRIB3) plays a crucial role in the anti-cancer activity of cannabinoids and that TRIB3 genetic inactivation enhances cancer generation and progression. PMID: 26517935
- TRB3 is an important mediator of palmitate-induced apoptosis in human liver cells, suggesting that it may also be involved in the molecular mechanism underlying PNALD. PMID: 24685558
- TRB3 is a novel profibrotic mediator in SSc. TGF-beta induces TRB3, which in turn activates canonical TGF-beta/Smad signaling and stimulates the release of collagen, creating a positive feedback loop that may contribute to aberrant TGF-beta signalling in SSc. PMID: 25603829
- Suggest a role of TRIB3 low-frequency variants on coronary artery disease risk among Italian patients with T2D. PMID: 26253791
- The results of the present study suggested that TRIB3 was associated with high glucose-induced HUVECs apoptosis, which was attenuated following transfection with TRIB3 siRNA. PMID: 25845379
- These results implicate TRIB3 and IGFBP2, both of which are known to be overexpressed in several types of cancers, as pro-survival modulators of cell viability in nutrient-deficient microenvironments. PMID: 26094770
- Trib3 interferes with the Parkinson's disease-associated prosurvival protein Parkin to mediate death PMID: 26224857
- These observations support the notion that loss of TRIB3 is associated with a more aggressive phenotype in various types of tumors by enhancing the activity of the mTORC2/AKT/FOXO axis. PMID: 25168244
- smoking and the TRIB3 G-allele is associated with an increased risk of diabetic nephropathy, which supports the hypothesis that oxidative stress contributes to the development of diabetic nephropathy PMID: 25447894
- The correlation between TRB3 and Notch 1 expression revealed that Notch 1 was downregulated by the knockdown of TRB3 in the lung adenocarcinoma cell lines. PMID: 23632994
- Tribbles 3 mediates endoplasmic reticulum stress-induced insulin resistance in skeletal muscle. PMID: 23695665
- Results demonstrate that both TRB3 and p21(Cip1) are critical molecules in the homocysteine signaling cascade. PMID: 23349842
- We discuss the role of Tribs as central signaling mediators in different subtypes of acute leukemia and propose that inhibition of dysregulated Trib signaling may be therapeutically beneficial. PMID: 23550039
- TRIB3 protein is a stable protein which levels are predominantly regulated by translational control of TRIB3 mRNA transcript in breast cancer PMID: 23185332
- Data indicate a dominant role for TRB3 and MAPK-ERK/TGFbeta pathways as Notch regulators in breast cancer, establishing TRB3 as a potential therapeutic target. PMID: 23319603
- TRB3, through its own cleavage, functions as a molecular switch between the cell survival and apoptotic pathways under stressful conditions PMID: 22912727
- Tribbles 3 protects nuclear DNA from cytidine deamination by APOBEC3A PMID: 22977230
- molecular mechanisms underlying metabolic and cardiovascular abnormalities [review] PMID: 22577090
- TRIB3 is independently associated with poor prognosis of breast cancer patients, possibly through its association with tumor cell hypoxia PMID: 21864376
- Studies indicate tribbles 1 and tribbles 3 as regulators of lipid level and disease susceptibility genes in metabolic syndrome and type 2 diabetes. PMID: 22274752
- TRIB3 protein is associated with a good prognosis in human breast cancer patients, possibly due to the fact that TRIB3 is involved in hypoxia tolerance. PMID: 21704407
- knockdown of endogenous TRB3 expression inhibited the migration and invasion of tumor cells in vitro PMID: 21896644
- TRB3 is a critical molecule in the homocysteine-mediated cell-cycle arrest in endothelial cells. PMID: 21935927
- TRB3 Q84R polymorphism is associated with obesity and especially glucose metabolism and not associated with polycystic ovary syndrome because of compositional characteristics of phenotype in Chinese PCOS women. PMID: 21492415
- HHcy impairs hepatic glycogen synthesis by inducing the expression of TRB3 PMID: 21435438
- the GCN2/eIF2alpha/ATF4 pathway is essential for the induction of the TRB3 gene transcription PMID: 21203563
- Helicobacter pylori infection is associated with decreased expression of TRIB3 in human gastric epithelial cell lines and tissue samples. PMID: 21220698
- The TRIB3 R84 variant is associated with increased carotid IMT also in Caucasians, thus replicating previous data obtained in Asians. In addition, in HUVECs, this variant is associated with unbalanced insulin signalling. PMID: 20693163
- Study have found evidence for a role of aberrant hepatic TRIB3 transcript levels in insulin resistance in obese humans and identified potential transcriptional pathways involved in regulation of TRIB3 gene expression in the liver. PMID: 20461355
- The pseudokinase tribbles homolog 3 interacts with ATF4 to negatively regulate insulin exocytosis in human and mouse beta cells. PMID: 20592469
- Data confirm that the TRIB3 R84 variant affects glucose homeostasis and suggest this effect is due to an alteration of the interplay between insulin sensitivity and secretion. PMID: 20393693
顯示更多
收起更多
-
亞細(xì)胞定位:Nucleus.
-
蛋白家族:Protein kinase superfamily, CAMK Ser/Thr protein kinase family, Tribbles subfamily
-
組織特異性:Highest expression in liver, pancreas, peripheral blood leukocytes and bone marrow. Also highly expressed in a number of primary lung, colon and breast tumors. Expressed in spleen, thymus, and prostate and is undetectable in other examined tissues, includ
-
數(shù)據(jù)庫鏈接:
Most popular with customers
-
-
YWHAB Recombinant Monoclonal Antibody
Applications: ELISA, WB, IHC, IF, FC
Species Reactivity: Human, Mouse, Rat
-
Phospho-YAP1 (S127) Recombinant Monoclonal Antibody
Applications: ELISA, WB, IHC
Species Reactivity: Human
-
-
-
-
-